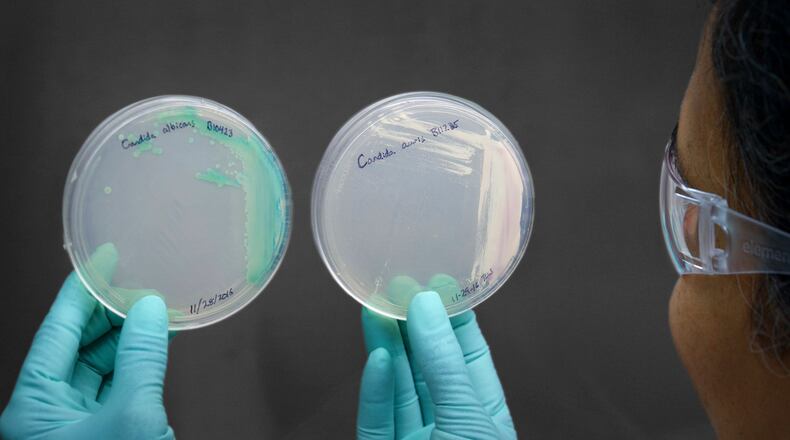
An undated photo provided by the Centers for Disease Control and Prevention shows a cultured Candida auris, right, and cultured Candida alibicans. The World Health Organization has released a ranking of fungi that threaten human health in its most ambitious effort to draw attention to a constellation of pathogens that are largely overlooked, even as they have become increasingly widespread, resistant to treatment and deadly. (Centers for Disease Control and Prevention via The New York Times) — NO SALES; FOR EDITORIAL USE ONLY —

Last year, 79 clinical cases were reported in Ohio, according to the CDC.
“We do have Candida Auris cases in Butler County, and unfortunately, Southwest Ohio has a high burden of cases,” said Erin Smiley, health promotion director with the Butler County General Health District.
The number of C. auris cases that were resistant to echinocandins, an antifungal medicine, tripled in 2021, according to the CDC. The fungus spreads easily in healthcare facilities and can cause severe infections with high death rates, the CDC said.
“C. auris is an emerging drug-resistant fungus that is a global concern,” Smiley said. “It lives on the skin, but if it becomes invasive, it can cause severe problems and even death.”
C. auris is generally not a threat to healthy individuals, but those who are at increased risks of acquiring it include people who are very sick, have invasive medical devices, or have long or frequent stays in health care facilities.
“The rapid rise and geographic spread of cases is concerning and emphasizes the need for continued surveillance, expanded lab capacity, quicker diagnostic tests, and adherence to proven infection prevention and control,” said CDC epidemiologist Dr. Meghan Lyman, lead author of a new paper from the CDC on this fungal infection.
C. auris, a microscopic fungus that grows as yeast, was first reported in 2016. Between 2016 and the end of 2021, a total of 3,270 clinical cases were reported in which infection was present and 7,413 screening cases in which the fungus was detected but not causing infection, the CDC said. Clinical cases increased each year since 2016, with the most rapid rise occurring during 2020-2021. Case counts continued to increase in 2022.
“C. auris is concerning as it is a drug-resistant fungus that can cause serious infections, particularly in patients in hospitals and long-term care facilities,” said Allison Combs, public information officer with the Warren County Health District. “We continue to work closely with the Ohio Department of Health and regional partners to identify cases. Early detection and infection control can limit the spread of C. auris. In Warren County, there has been two cases reported thus far for 2023, and in 2022, there were also two reported cases for the entire year.”
One of the challenges to keeping track of C. auris cases is a lack of communication between health care facilities, Smiley said.
“For example, if a patient with C. auris is transferred to another facility, often that information is not relayed partly because they may not have been placed on enhanced barrier precautions,” Smiley said. “The C. Auris Multi Drug Resistant Organism Work group, made up of public health, hospital networks, and infection control practitioners, along with the Stop C. Auris Regional Effort, a collaboration with the Ohio Department of Health and Health Departments, are working on prevention strategies.”
There were no reported outbreaks of the fungal infection in Montgomery County, according to Public Health - Dayton and Montgomery County. The Clark County Combined Health District said they have no reports of C. auris in Clark County in five years. There have also been no reports in Greene County, according to Greene County Public Health.
Some health departments are screening for C. auris at local nursing homes.
“Candida auris can be found on the skin of people and not cause them to be sick at all,” said Dr. Becky Thomas, medical director for Public Health - Dayton and Montgomery County. For others, if the fungus leads to an internal infection, can have severe health outcomes.
“It’s something that’s out there, but it’s going to affect people differently,” said Dan Suffoletto, Public Health’s public information manager.
This fungal infection can be difficult to diagnose, so public health officials say this is something for health care providers to look for, such as if a patient has an infection that is not healing.
“It has become resistant to the most common antifungals,” Thomas said.
Individuals, especially close contacts for individuals who are immunocompromised, should continue making sure they wash their hands and practice good hygiene, health officials said.
About the Author